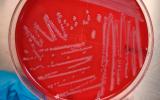

La #LíneadeSaludAnimal centra sus esfuerzos en la búsqueda, aislamiento y caracterización de nuevas especies bacterianas benéficas, con potencial aplicación en la acuicultura y en la promoción de la salud de organismos marinos. Estas bacterias son monitoreadas en diversos ambientes naturales, los cuales están influenciados tanto por la actividad de la industria acuícola como por el impacto antropogénico, factores que generan cambios significativos en la dinámica microbiana. Este contexto se convierte en un desafío constante para los investigadores, quienes buscan asegurar la correcta identificación y comprobación de los microorganismos hallados, evaluando sus propiedades beneficiosas y su posible utilización como alternativas sostenibles para el control de patógenos y la mejora de la productividad acuícola.
28-nov-2025